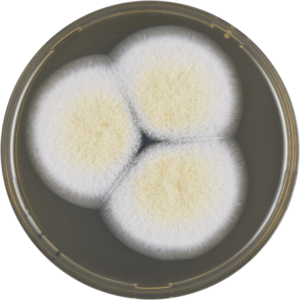

Aspergillus sclerotiorum الإنجليزية (Q282432)
نوع من الفطريات
| اللغة | التسمية | الوصف | أسماء أخرى |
|---|---|---|---|
| العربية | لم تُضف التسمية |
نوع من الفطريات |
|
| الإنجليزية | Aspergillus sclerotiorum |
species of fungus |
بيانات
Wikidata item الإنجليزية
taxon name الإنجليزية
taxon rank الإنجليزية
instance of الإنجليزية
parent taxon الإنجليزية
taxon common name الإنجليزية
Google Knowledge Graph ID الإنجليزية
image الإنجليزية
Aspergillus sclerotiorum cya.png
٣٬٤٢٤ × ٣٬٤٢٤؛ ٣٫٧٧ ميجابايت
٣٬٤٢٤ × ٣٬٤٢٤؛ ٣٫٧٧ ميجابايت
١ مراجع
Imported from Wikidata item الإنجليزية
Aspergillus sclerotiorum meaox.png
٣٬٤٠٠ × ٣٬٤٠٠؛ ٣٫٤١ ميجابايت
٣٬٤٠٠ × ٣٬٤٠٠؛ ٣٫٤١ ميجابايت
١ مراجع
Imported from Wikidata item الإنجليزية
Commons category الإنجليزية
short name الإنجليزية